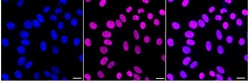
Invitrogen RCC1 Recombinant Rabbit Monoclonal Antibody (24GB4175) 20 &mu;L;

missing translation for 'onlineSavingsMsg'
Learn More
Learn More
Invitrogen™ RCC1 Recombinant Rabbit Monoclonal Antibody (24GB4175)
Rabbit Recombinant Monoclonal Antibody
Brand: Invitrogen™ MA557216
This item is not returnable.
View return policy
Description
RCC1 Recombinant Monoclonal Antibody for Western Blot, ICC/IF, Flow
Guanine-nucleotide releasing factor that promotes the exchange of Ran-bound GDP by GTP. Involved in the regulation of onset of chromosome condensation in the S phase. Binds both to the nucleosomes and double-stranded DNA. RCC1-Ran complex (together with other proteins) acts as a component of a signal transmission pathway that detects unreplicated DNA. Plays a key role in nucleo-cytoplasmic transport, mitosis and nuclear-envelope assembly.
Specifications
| RCC1 | |
| Recombinant Monoclonal | |
| Unconjugated | |
| RCC1 | |
| 4931417M11Rik; AI326872; Cell cycle regulatory protein; chc1; chc1-a; chromosome condensation 1; chromosome condensation protein 1; fj77f08; guanine nucleotide-releasing protein; RanGEF; RCC1; rcc1.L; rcc1-a; rcc1-b; RCC1-I; Regulator of chromosome condensation; regulator of chromosome condensation 1; regulator of chromosome condensation 1 L homeolog; SNHG3-RCC1; SNHG3-RCC1 readthrough; wu:fj77f08; XELAEV_18012073mg; xrcc1; zgc:65796; zgc:77114 | |
| Rabbit | |
| Affinity chromatography | |
| RUO | |
| 100088, 1104, 682908 | |
| -20°C | |
| Liquid |
| Flow Cytometry, Western Blot, Immunocytochemistry | |
| 24GB4175 | |
| PBS with 50% glycerol and 0.02% sodium azide; pH 7.4 | |
| P18754, Q8VE37 | |
| RCC1 | |
| A synthesized peptide derived from human RCC1 (aa 10-50). | |
| 20 μL | |
| Primary | |
| Human, Mouse, Rat | |
| Antibody | |
| IgG |
Product Content Correction
Your input is important to us. Please complete this form to provide feedback related to the content on this product.
Product Title
Spot an opportunity for improvement?Share a Content Correction